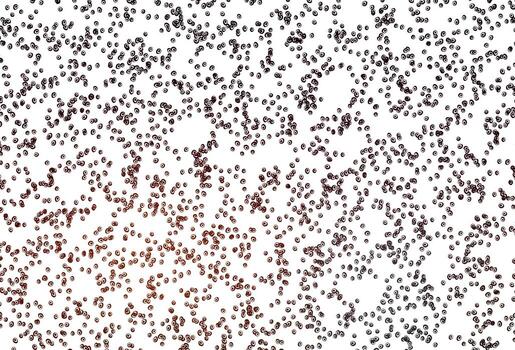
Light Red vector template with circles.

Vectors
Photos
Videos
Editorial
More


 My Collections
My Collections
Trending Searches
Top SearchesTrending Searches
Top SearchesTrending Searches
Top Searches


Vectors
Trending Searches
Vector Pages
Photos
Trending Searches
Photo Pages
Videos
Trending Searches
Video Pages
Editorial
0